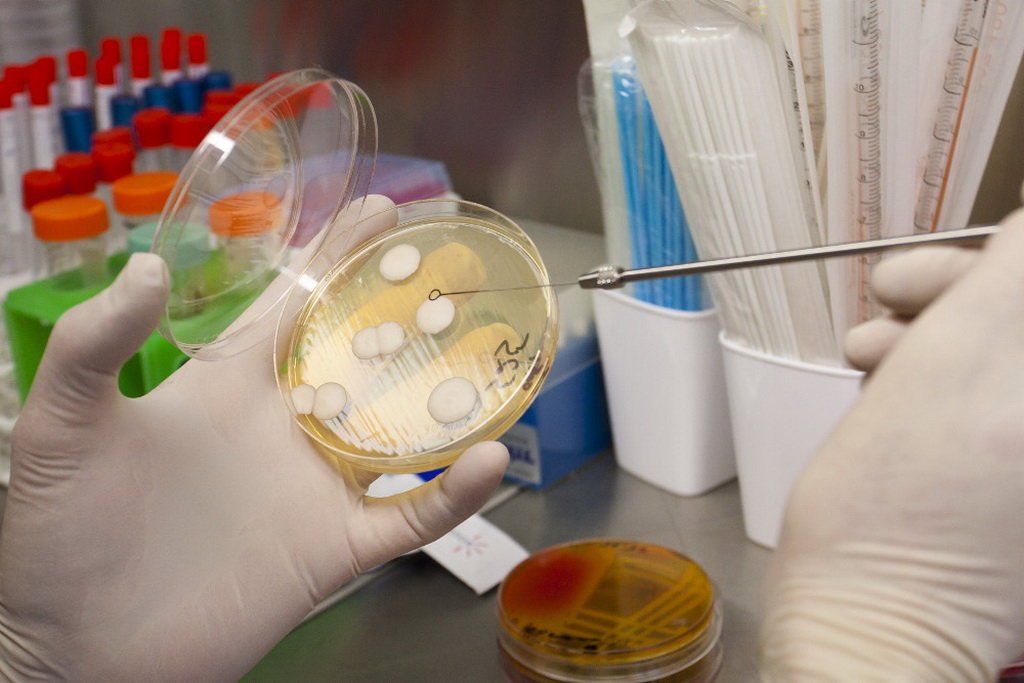

Главная
/
УЗИ надпочечников
УЗИ надпочечников в Медицинском центре Финист
Акции и скидки

Для детей—инвалидов скидка 20%
Срок действия
Постоянная акция

«Как я провёл лето»
Срок действия
Постоянная акция

Для детей из многодетных семей 20% скидка
Срок действия
Постоянная акция
Фотогалерея

Отзывы
5,0
Мария
Отличный доктор, профессионал с большой буквы!
26 апреля 2022 Отзыв взят с сайта Zoon.ru
5,0
Александр Куринный
Преимущества: Выражаю огромную благодарность за профессионализм и человеческую чуткость Морозовой Елене Анатольевне! Именно о таких врачах говорят - "врач от бога"! Благодаря ее усилиям и творческому подходу к выбору тактики лечения ,нам удалось добиться устойчивой ремиссии в лечении инфекции, от лечения которой ,как говориться ,"развели руки "во многих клиниках Москвы.
Лечусь у Елены Анатольевны более четырех лет и буду продолжать впредь. Отмечаю ,также высокое качество лабораторных исследований, выполняемых в КДЦ" ФИНИСТ".
18 ноября 2020 Отзыв взят с сайта Zoon.ru
0,0
Юля
Очень тяжело дозвониться!
Может быть, наладить услугу « обратный звонок»?
17 октября 2020, отредактирован 19 октября 2020 в 16:01 Отзыв взят с сайта Zoon.ru
5,0
Татьяна
Я приходила в этот центр на УЗИ. Мне очень понравилось то, как врач провел обследование. Специалист мне всё показал, подробно рассказал и разъяснил. К сожалению, не помню его фамилию, это был мужчина. Обслуживание в центре замечательное. Я немного не рассчитала время и опоздала на 10-15 минут. Ко мне отнеслись хорошо и не попрекали за опоздание. У меня не было неудобного ощущения. Мне сказали, что ничего страшного, чтобы я спокойно отдышалась, и скоро примут. Я три минуты подождала и зашла в кабинет. Мне было приятно такое отношение. Я скоро приду сюда ещё, уже записалась на приём к врачу.
1 ноября 2019 Отзыв взят с сайта Zoon.ru
5,0
Кристина
Елена Анатольевна Морозова опытный и квалифицированный специалист. У нас был сомнительный анализ, который доктор нам расшифровала, подробно рассказала, что все это значит. Были назначены расширенные исследования, которые должны помочь прояснить картину. Мы очень довольны качеством работы этого доктора и обслуживанием в центре, поэтому в случае необходимости будем обращаться.
17 октября 2019 Отзыв взят с сайта Zoon.ru
5,0
Татьяна
Мне понравилось участие доктора и то, что приём был по делу. Елена Анатольевна Морозова профессиональный специалист и мне было приятно с ней общаться. Я посетила данного доктора по рекомендации своей знакомой. Центр мне понравился в целом. Прим был даже раньше назначенного времени. Персонал на ресепшене внимательный и приветливый. Я дозвонилась в центр с первого раза.
17 октября 2019 Отзыв взят с сайта Zoon.ru
5,0
Анонимный пользователь
Я бываю в центре редко, приезжаю сюда в основном сдавать анализы. Лаборатория здесь просто уникальная. Я не знаю, как это делают сотрудники, но они всегда обнаруживают то, чего ни в одной клинике не находили. Качество услуг здесь просто отличное, да и цены достаточно демократичные. У меня жена болела пневмонией, лежала в больнице и сдавала там анализы, но ничего не могли найти. Приехали сюда и сразу всё обнаружили. И таких случаев предостаточно, когда лаборатория этого центра нас выручала. Я живу в другом конце Москвы, но если возникает необходимость, то всегда еду сюда.
10 октября 2019 Отзыв взят с сайта Zoon.ru
5,0
Мария
Я обслуживаюсь у доктора Ольги Владимировны Ериловой. Мне нравится ее высокий профессионализм. Доктор внимательна к пациентам и аккуратно оказывает услуги. Также мне нравится качественная работа персонала.
8 октября 2019 Отзыв взят с сайта Zoon.ru
5,0
Наталья
Мне понравился доктор УЗИ Герман Васильевич Климин. Он всё подробно и доступно рассказал и объяснил. Очень грамотный специалист, профессионал в своём деле. Приём был по времени. Очень приятная и вежливая девушка на ресепшене. Мне всё понравилось.
27 сентября 2019 Отзыв взят с сайта Zoon.ru
5,0
Светлана
Я была на УЗИ у доктора Климина. Доктор мне нравится: внимательный, наблюдает меня давно. На процедуре все объяснил, все замечательно. Впечатление о центре доброжелательное, приняли меня вовремя.
21 сентября 2019 Отзыв взят с сайта Zoon.ru
4,0
Анонимный пользователь
Я уже давно посещаю специалиста - Ольгу Владимировну Ерилову. Мне нравится ее отношение. Единственное, в последнее посещение мне не удалось задать все вопросы, которые хотела, не была предоставлена возможность. Принимают всегда вовремя. В центре немного устаревший интерьер, но чисто. В целом я довольна работой специалиста.
18 сентября 2019 Отзыв взят с сайта Zoon.ru
5,0
Василий
Пользуюсь услугами только Елены Анатольевны Морозовой в этом центре. Это доктор не просто с большой буквы, а профессионал, одна из немногих на всю Москву. Все качества, которыми должен обладать настоящий врач, в ней присутствуют.
12 сентября 2019 Отзыв взят с сайта Zoon.ru
5,0
Наталья
В клинике я была с ребенком на приеме у инфекциониста Елены Валериевны Мелехиной. Врач адекватно провела осмотр, все доступно нам объяснила, назначила лечение. Единственное, на мой взгляд, цены на услуги в центре высокие.
12 сентября 2019 Отзыв взят с сайта Zoon.ru
5,0
Екатерина
На протяжении нескольких лет я хожу в этот центр. Мне очень нравится работа специалиста Ольги Владимировны Ериловой. Всегда отличные консультации и действующие рекомендации. Лечение качественное. Цена меня устраивает. Администраторы доброжелательны, документы подготавливают быстро.
29 июля 2019 Отзыв взят с сайта Zoon.ru
5,0
Анонимный пользователь
Понравился прием специалиста Морозовой Елены Анатольевны. Очень подробно проконсультировала меня по моей проблеме. Дала мне хорошие рекомендации и назначения.
24 июля 2019 Отзыв взят с сайта Zoon.ru
5,0
Ксения
Я была с ребенком в этой клинике впервые. Специалист Елена Валериевна Мелехина, внимательно выслушала, дала адекватные рекомендации. Отличный подход к ребенку. Документы на ресепшене оформили быстро, администраторы вежливые.
17 июля 2019 Отзыв взят с сайта Zoon.ru
5,0
Нина
Я с ребенком впервые посещала этот центр. Мы пришли именно к врачу Елене Валериевне Мелехиной, по рекомендации. Видно, что врач находится на своем месте, она понимает, о чем говорит и учла все моменты, которые были связаны с ребенком.
15 июля 2019 Отзыв взят с сайта Zoon.ru
5,0
Дженет
Были с ребенком на приеме у Елены Валериевны Мелехиной. Понравилось отношение врача к ребенку. Она полностью и тщательно осмотрела ребенка. Дала необходимые рекомендации. Теперь мы ждем результаты анализов и назначения дальнейшего лечения.
10 июля 2019 Отзыв взят с сайта Zoon.ru
5,0
Кристина
Была в этом центре впервые. Мне понравилась работа специалиста Ольги Владимировны Ериловой. Отличная консультация и рекомендации. Ответили на все мои вопросы. Хорошее отношение к пациентам. Девочки на ресепшене были доброжелательны. Цены тут доступные.
7 июля 2019 Отзыв взят с сайта Zoon.ru
4,0
Никита
Я был на приеме у терапевта Ольги Владимировны Ериловой. Не очень устроило, что специалист не уделила внимание осмотру, посчитала это ненужным. Обычно терапевт первоначально должен сделать визуальный осмотр, послушать клиента, измерить давление, посмотреть горло. Моей проблемой была болезнь горла. Специалист посчитала ненужным его смотреть, начала задавать вопросы и направлять на анализы. Я понимаю, что на основе анализов строится дальнейшее лечение, но осмотр нужно было провести. Центр находится далеко от метро, но внутри нормальная атмосфера, прием осуществляется вовремя.
7 июля 2019 Отзыв взят с сайта Zoon.ru
5,0
Ирина
13 июня с дочкой (7 лет) сдавали анализы по поводу инфекционного мононуклеоза. Врач направила в этот центр, т.к. тут делают исследования на культуре клеток, а в Москве очень мало медцентров осуществляют такие услуги, особенно по герпесвирусам.
Обычно у нас сдача крови - отдельная мелодрама, но в этот раз все прошло как по маслу, за что большое спасибо медсестре Алсу - к ребенку относилась с сочувствием, поддерживала, даже конфетку дали - мелочь, а отношение у ребенка меняет!
Результаты получили даже раньше, что позволило быстрее разобраться с болезнью.
В общем, впечатления остались только положительные)
28 июня 2019 Отзыв взят с сайта Zoon.ru
0,0
Кирилл
Из минусов - не дозвонился с первого раза. Но это скорее придирки. Очень понравился прием Ериловой. Толковый врач, от нее выходил под большим впечатлением, правда выписала кучу препаратов. Но судя по их описанию они даже мертвого вылечат
28 июня 2019 Отзыв взят с сайта Zoon.ru
0,0
Мария
Хотела оставить пару строк тут.
Финист-достаточно особенная клиника Москвы,самобытная своего рода.Мне необходимо было обследоваться на герпесвирусы культуральным методом и пневмоцистоз комплексно и оказалось,что такого рода исследования делаются только в этой клинике.Рада,довольна,удивлена.Все получилось на уровне))
28 июня 2019 Отзыв взят с сайта Zoon.ru
5,0
Ольга Александровна
Добрый день. 25.06.2019г. сдавала кровь на целый ряд исследований в процедурном кабинете медицинского центра ООО "ФИНИСТ". Волновалась страшно (взятие крови из вены для меня всегда волнительная процедура). Волнение оказалось напрасным: кровь взяли быстро и профессионально; даже толком испугаться не успела, без синяков, без разговоров о плохих венах. До этого сдавала кровь в районной поликлинике - искололи обе руки, замучили пока попали в вену, синяки на обеих руках (объяснили, что плохие вены).
После меня в процедурный кабинет вошла мама с грудничком. Думала, что начнется крик, плач. Ничего подобного. Быстро, тихо. Когда они вышли из кабинета, специально спросила: "Что сдавали". Мама сказала, что кровь из вены, что они сдают в этом медицинском центре не первый раз (в семье есть еще детки), что у них есть скидки для многодетных семей.
Уважаемые медсестры ООО "ФИНИСТ"! Огромное вам спасибо за внимание, доброту и терпение, и, конечно, профессионализм.
С глубоким уважением, Ольга Александровна
27 июня 2019 Отзыв взят с сайта Zoon.ru
5,0
Сергей Александрович
Добрый день!
Мне уже за 50 и, к сожалению, болезни подступают. Возникла срочная необходимость сделать комплексные и сложные анализы по целому набору (насколько я понял не часто запрашиваемых) показателей, которые помогут моему лечащему врачу назначить оптимальный курс лечения. Естественно волновался, т.к. лабораторий в Москве вроде много, но.... сами понимаете, качество может быть разное, а здоровье у меня одно. Обратился в "Финист" и достаточно быстро получил результаты за вполне приемлемые деньги. Мой лечащий врач, когда я принес ему результаты, был приятно удивлен и произнес "сразу видно анализы делали специалисты - настоящие ученые". Огромное спасибо за качество и оперативность! Если возникнет необходимость, буду теперь обращаться прежде всего сюда, родным и знакомым также спокойно рекомендую.
26 июня 2019 Отзыв взят с сайта Zoon.ru
0,0
Татьяна
Добрый день! Хочу написать огромную благодарность доктору Ериловой Ольге Владимировне. У моей дочери сильно падал иммунитет и в связи с этим появился целый букет побочных заболеваний. Врачи не знали, чем помочь, хоть дочка и проходила обследования. Мы не понимали, что с ней происходит. И тогда мне посоветовали обратиться к Ольге Владимировне. Я очень благодарна ей за помощь дочери, за высокий профессионализм, за чуткое отношение к пациентам!!! Отдельно хочу отметить, что лечение прописанное Ольгой Владимировной было очень бережным, что для моей дочери очень актуально учитывая сколько капельниц с сильными препаратами ей пришлось перенести ранее. Ещё раз ОГРОМНОЕ спасибо за профессиональную помощь!!! Оцениваю работу мед.центра на отлично!
26 июня 2019 Отзыв взят с сайта Zoon.ru
0,0
Елена
Переходный период (климакс) в моей жизни начался как-то неожиданно. Повышенное давление, панические атаки, прохой сон и как следствие усталость, не хватка сил... За помощью обратилась к врачу Морозовой Елене Анатольевне. Прошла обследование, подобрали медикаменты и жизнь снова обрела Краски! Низкий поклон Вам!
26 июня 2019 Отзыв взят с сайта Zoon.ru
1,0
Светлана
Наглый и черствый прием администратора. Не пыталась даже разобраться. А пришли мы на прием с маленьким ребенком, годик и восемь месяцев!!!!!! Как пришли, так и ушли....Удивительно, что в таком месте сталкиваешься с полным равнодушием и хамством.
29 ноября 2018 Отзыв взят с сайта Zoon.ru
0,0
Анонимный пользователь
Приехал в 8.50 , пишут , что работают с 9.00 . Дождался 9.10 ,закрыто . Дошёл до проходной института , от туда позвонила вахтёрша ей ответили , что они там с 8.00. Вернулся в 9.25 , только открылись. Персонал еле двигается. Спросили ,как буду получать результаты анализа на руки или по электронной почте, оставил почту. Сдал анализы 19.01.2017г. , результат сказали будет готов 27.01.2017. , позвонил 30.01.2017. спросили , а вы адрес оставляли ? Просили отправить письмо - запрос на электронку. Отправил !!! Сегодня 03.02.2017. , а результат я так и не получил. Сервис за наши деньги НИ КАКОЙ!!!!!
3 февраля 2017 Отзыв взят с сайта Zoon.ru
5,0
Елена Юрьевна
Матюхин Андрей Игоревич - детский врач УЗИ диагностики

1 апреля 2016 Отзыв взят с сайта Zoon.ru
Удалить отзыв
Популярные услуги
УЗИ
уточняйте по телефону
Анализ на коронавирус
уточняйте по телефону
Диагностический центр
уточняйте по телефону
Вызов врача на дом
уточняйте по телефону
Скрининг
уточняйте по телефону
ПЦР-тест на коронавирус
уточняйте по телефону
Анализ на антитела к коронавирусу
уточняйте по телефону
Физиотерапия
уточняйте по телефону
Онкология
уточняйте по телефону
УЗИ ребенку
уточняйте по телефону
Остались вопросы?
Вы можете воспользоваться любым из указанных способов связи
Контактный номер
+7 (499) 193-30-...
Показать